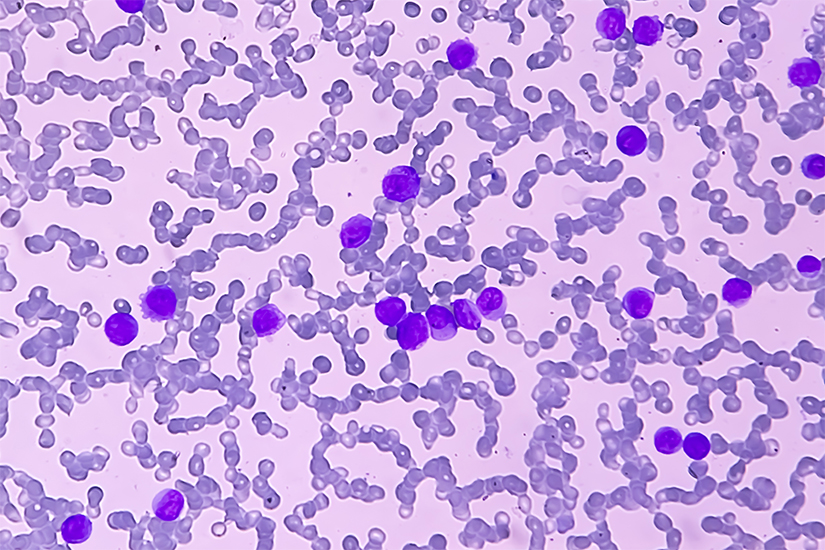

Iata cateva dintre alimentele care cresc monocitele:
1. Legumele cu frunze verzi – Acestea contin o multime de nutrienti, inclusiv vitamina A, vitamina C si fier, care pot ajuta la cresterea nivelului de monocite din sange.
2. Citricele – Fructele citrice sunt bogate in vitamina C, un nutrient important pentru sistemul imunitar si cresterea monocitelor.
3. Usturoiul – Usturoiul contine compusi sulfurici care ajuta la stimularea sistemului imunitar si la cresterea nivelului de monocite din sange.
4. Ghimbirul – Acesta are proprietati antiinflamatorii si poate ajuta la cresterea nivelului de monocite din sange.
5. Nucile – Nucile sunt bogate in magneziu, un nutrient important pentru sistemul imunitar si cresterea monocitelor.
Este important de retinut ca o dieta echilibrata si variata este cea mai buna optiune pentru cresterea nivelului de monocite din sange. In plus, este intotdeauna recomandat sa discutati cu medicul dumneavoastra inainte de a face orice modificare majora a dietei sau stilului de viata.
1. Ce sunt monocitele?
Monocitele sunt un tip de celule sanguine albe care joaca un rol important in sistemul imunitar al organismului.
2. De ce este important sa cresteti nivelul de monocite din sange?
Nivelul de monocite din sange poate varia in functie de starea de sanatate a unei persoane, dar cresterea acestor celule sanguine poate ajuta la lupta impotriva infectiilor si inflamatiilor, precum si la eliminarea celulelor moarte sau deteriorate din corp.
3. Ce alimente pot ajuta la cresterea nivelului de monocite din sange?
Alimente precum legumele cu frunze verzi, citricele, usturoiul, ghimbirul si nucile pot ajuta la cresterea nivelului de monocite din sange.
Daca ai intrebari sau doresti sa impartasesti experienta ta cu alimentele care cresc monocitele, te invitam sa lasi un comentariu mai jos.
Alimente Care Cresc Albumina
Albumina este o proteina care se gaseste in plasma sangelui si este esentiala pentru mentinerea unei functii optime a corpului. Nivelele scazute de albumina pot fi cauzate de o varietate de factori inclusiv malnutritie boli cronice si afectiuni renale. Pentru a creste nivelele de albumina este impor – cv-inginer.ro

Alimente Care Cresc Ureea Serica
Alimentele care cresc ureea serica sunt alimente bogate în proteine cum ar fi carnea peștele ouăle produsele lactate și produsele de soia. De asemenea alimentele bogate în fier cum ar fi spanacul fasolea mazărea lintea și cânepa sunt de asemenea cunoscute pentru a crește ureea serica. Aceste aliment – cv-inginer.ro

Alimente Care Cresc Tensiunea Arteriala
Alimentele care cresc tensiunea arteriala sunt produse alimentare care au un efect artificial asupra tensiunii arteriale crescand-o. Acestea includ alimente bogate in sare grasimi saturate alimente procesate zahar si produse alcoolice. Alte alimente care pot contribui la creșterea tensiunii arterial – cv-inginer.ro

Alimente Care Scad Vsh
Alimentele care scad VSH (în mod obișnuit cunoscute ca alimente care scad tensiunea arterială) sunt alimente care pot ajuta la menținerea unei tensiuni arteriale sănătoase. Acestea pot include alimente cu conținut scăzut de grăsimi saturate și colesterol precum și fructe și legume bogate în potasiu – cv-inginer.ro

Alimente Care Constipa
Constipatia este o problema comuna pentru multe persoane si poate fi cauzata de mai multi factori inclusiv alimentatie. Anumite alimente pot agrava constipatia in timp ce altele pot ajuta la prevenirea sau ameliorarea acesteia. In acest articol vom discuta despre alimentele care constipa si cele car – cv-inginer.ro

Bauturi Care Cresc Tensiunea
Bauturile care cresc tensiunea sunt bauturi energizante si alte bauturi carbogazoase ce contin cofeina taurina si alte stimulente care provoaca cresterea tensiunii arteriale. Aceste bauturi pot oferi o crestere temporara a energiei si a performantei dar in general nu sunt recomandate pentru persoane – cv-inginer.ro

Alimente Care Calmeaza Arsurile La Stomac
Alimentele care calmeaza arsurile la stomac sunt alimente bogate in fibre care ajuta la prevenirea acidului gastric si la reducerea iritatiilor stomacului. Acestea pot include legume si fructe bogate in fibre cum ar fi broccoli varza spanac mere pere prune banane si stafide. De asemenea alimente cu – cv-inginer.ro

Alimente Care Scad Tensiunea
Alimentele care scad tensiunea sunt alimente bogate in nutrienti si antioxidanti care pot ajuta la reducerea nivelului de presiune sanguina. Acestea includ fructe legume orez brun seminte alune fasole peste oua produse lactate produse din cereale integrale nuci si uleiuri sanatoase. Aceste alimente – cv-inginer.ro

Alimente Care Scad Acidul Uric
Alimentele care scad acidul uric sunt un set de produse alimentare care ajuta la reducerea nivelurilor crescute de acid uric din organism. Aceste produse alimentare sunt bogate în nutrienți și pot ajuta la scăderea inflamației și la îmbunătățirea stării de sănătate. Acestea includ produse lactate fr – cv-inginer.ro

Alimente Care Te Strang La Stomac
Daca iti este greu sa digeri mancarea dupa masa si simti o senzatie de disconfort la stomac nu esti singurul. Multi oameni experimenteaza acest lucru iar cauzele pot fi diferite de la alimentatie pana la probleme de sanatate. In acest articol vom discuta despre alimentele care te strang la stomac si – cv-inginer.ro

Cum să creșteți monocitele în sânge în mod natural – Verificarea …
Monocitele sunt tipuri de celule albe din sânge care joacă un rol important … Anumite alimente care s-au dovedit a crește monocitele se numără în mod natural. – ro.waykun.com

Monocite: factori de risc care duc la creșterea de monocite – YVE.ro
22 ian. 2019 … Celulele albe din sânge poartă denumirea de monocite. … aceste alimente ajută la creșterea nivelului de imunitate a organismului și … – yve.ro

Monocitoza (monocite crescute) – cauze și afecțiuni ce determină …
3 oct. 2019 … Monocitoza reprezentată creșterea numărului de monocite în sânge, peste limita maximă normală a acestora. Monocitele reprezintă o categorie … – www.romedic.ro

Monocite crescute: cauze, simptome și tratament | DivaHair.ro
27 mar. 2018 … Vezi 10 alimente care îți întăresc sistemul imunitar! … leucocite (inclusiv monocitele), iar vitamina C creste imunitatea prin durata mai … – www.divahair.ro

Alimente pentru sănătatea monocitelor / Boli și condiții | Sport …
Monocitele, celulele albe din sânge mari care se transformă în macrofage în … Anumite alimente pot ajuta la mentinerea numarului de monocite in limite … – ro.lavozdeecuador.com

Monocitele din sânge: când nivelul lor este anormal și de ce …
11 mar. 2021 … Monocitele sunt un tip de celule „albe” sau leucocite din sânge și au un … zahăr și produsele dulci), alimente prăjite, băuturile dulci, … – sanoteca.md

Monocite crescute sau scăzute: cauze, simptome, valorile normale …
3 mai 2023 … Un nivel scăzut sau crescut de monocite poate semnala existența anumitor … se recomandă consumul de alimente antiinflamatoare, precum:. – www.csid.ro

Monocite crescute
29 mar. 2022 … Monocite crescute – Monocitele sunt tipuri de celule albe din sange, intalnite in sangele tuturor vertebratelor. Exista mai multe tipuri … – www.sfatulmedicului.ro

Monocitoza (numar crescut de monocite)
Urmatoarele conditii medicale pot creste numarul de monocite: … cu multe fructe si legume si limiteaza alimentele care provoaca inflamatii, … – www.reginamaria.ro
Monocite scazute | DivaHair.ro
18 mar. 2019 … Află care sunt cauzele monocitelor scăzute la analize, ce simptome apar și ce tratament trebuie să urmezi … Alimente care cresc monocitele. – www.divahair.ro

Lasă un răspuns